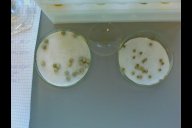

Impressionen
Experimentieren mit Färberpflanzen
Eindrücke interessanter Experimente aus den beiden Reihenheften. Experimentiert wurde hier mit Möhre, Rotkohl, Brennnessel, Löwenzahn und Petersilie.
Von der Chemotherapie zur zielgerichteten Krebstherapie
Erste Fortbildungsveranstaltung zum Thema: Krebs, Bedeutung des Cytoskeletts für den Ablauf der Mitose, Taxolwirkung am Mitosemodell und Krebstherapie im Unterricht. Lehrkräfte erstellen einen einfachen Stop-Motion-Film.
Auf Spurensuche - Medikamente und andere Stoffe im Wasser
Fortbildung über Medikamente im Wasserkreislauf und deren Wirkungen im Ökosystem und für den Menschen: Lehrkräfte aller Schulformen erprobten eine Projektbox, die in der Sek I im Kernunterricht, im Wahlpflichtbereich oder an Experimentiertagen und AGs eingesetzt werden kann.
Ökologie vor der Haustür
Untersuchung des Ökosystems Industriebrache am Ruhrmuseum in Essen. Behandlung von Aspekten wie Sukzession, Pionierpflanzen, Neophyten, Bodeneigenschaften, Erfassung von Tieren, Pflanzenbestimmung und Artenvielfalt.
Exkursion: Tropische Nutzpflanzen
Führung durch den botanischen Garten der Universität Duisburg-Essen, bei der Herkunft, Biologie, Anbau, Inhaltsstoffe und auch Geschmack verschiedenster tropischer Nutzpflanzen vorgestellt werden.
Neue Unterrichtsmaterialien zur Fließgewässerökologie für den Biologieleistungskurs
Darstellung des aktuellen Wissensstands zur ökologischen Fließgewässerbewertung; Vorstellung der Unterrichtsreihe und der Unterrichtsmaterialien (Überblick); Ökologische Zusammenhänge im Fließgewässer am Beispiel der Makrozoobenthos; Untersuchung eines Fließgewässers. Vorstellung des vorbereitenden Unterrichts, Auswertung der Exkursion und die Einbindung der Ergebnisse in den Unterricht.
Experimente für den Biologieunterricht
Vorstellung interessanter Versuche für den Biologieunterricht der Sekundarstufe I und II, die selbst erprobt und in verschiedene Unterrichtssettings/Unterrichtszusammenhänge eingeordnet werden können. Die Liste der vorgestellten Experimente kann hier eingesehen werden.
Interaktionsboxen und Egg-Races
Egg-Races und Interaktionsboxen stellen motivierende Methoden zur Einführung naturwissenschaftlichen Arbeitens und zur Förderung sozialer Kompetenzen dar. Im Rahmen des Workshops werden ein kurzer theoretischer Hintergrund gegeben und mehrere Beispiele für den Unterricht in der Sek. I vorgestellt, ausprobiert und im Hinblick auf die Einbindungsmöglichkeiten in den Unterricht diskutier.
Neobiota-Exkursion in die Saarner Ruhrauen in Mülheim an der Ruhr
Vorstellung und Beobachtung nicht-einheimischer Pflanzen und Tiere, Einordnung in den Lehrplan und Unterrichtsmaterial.